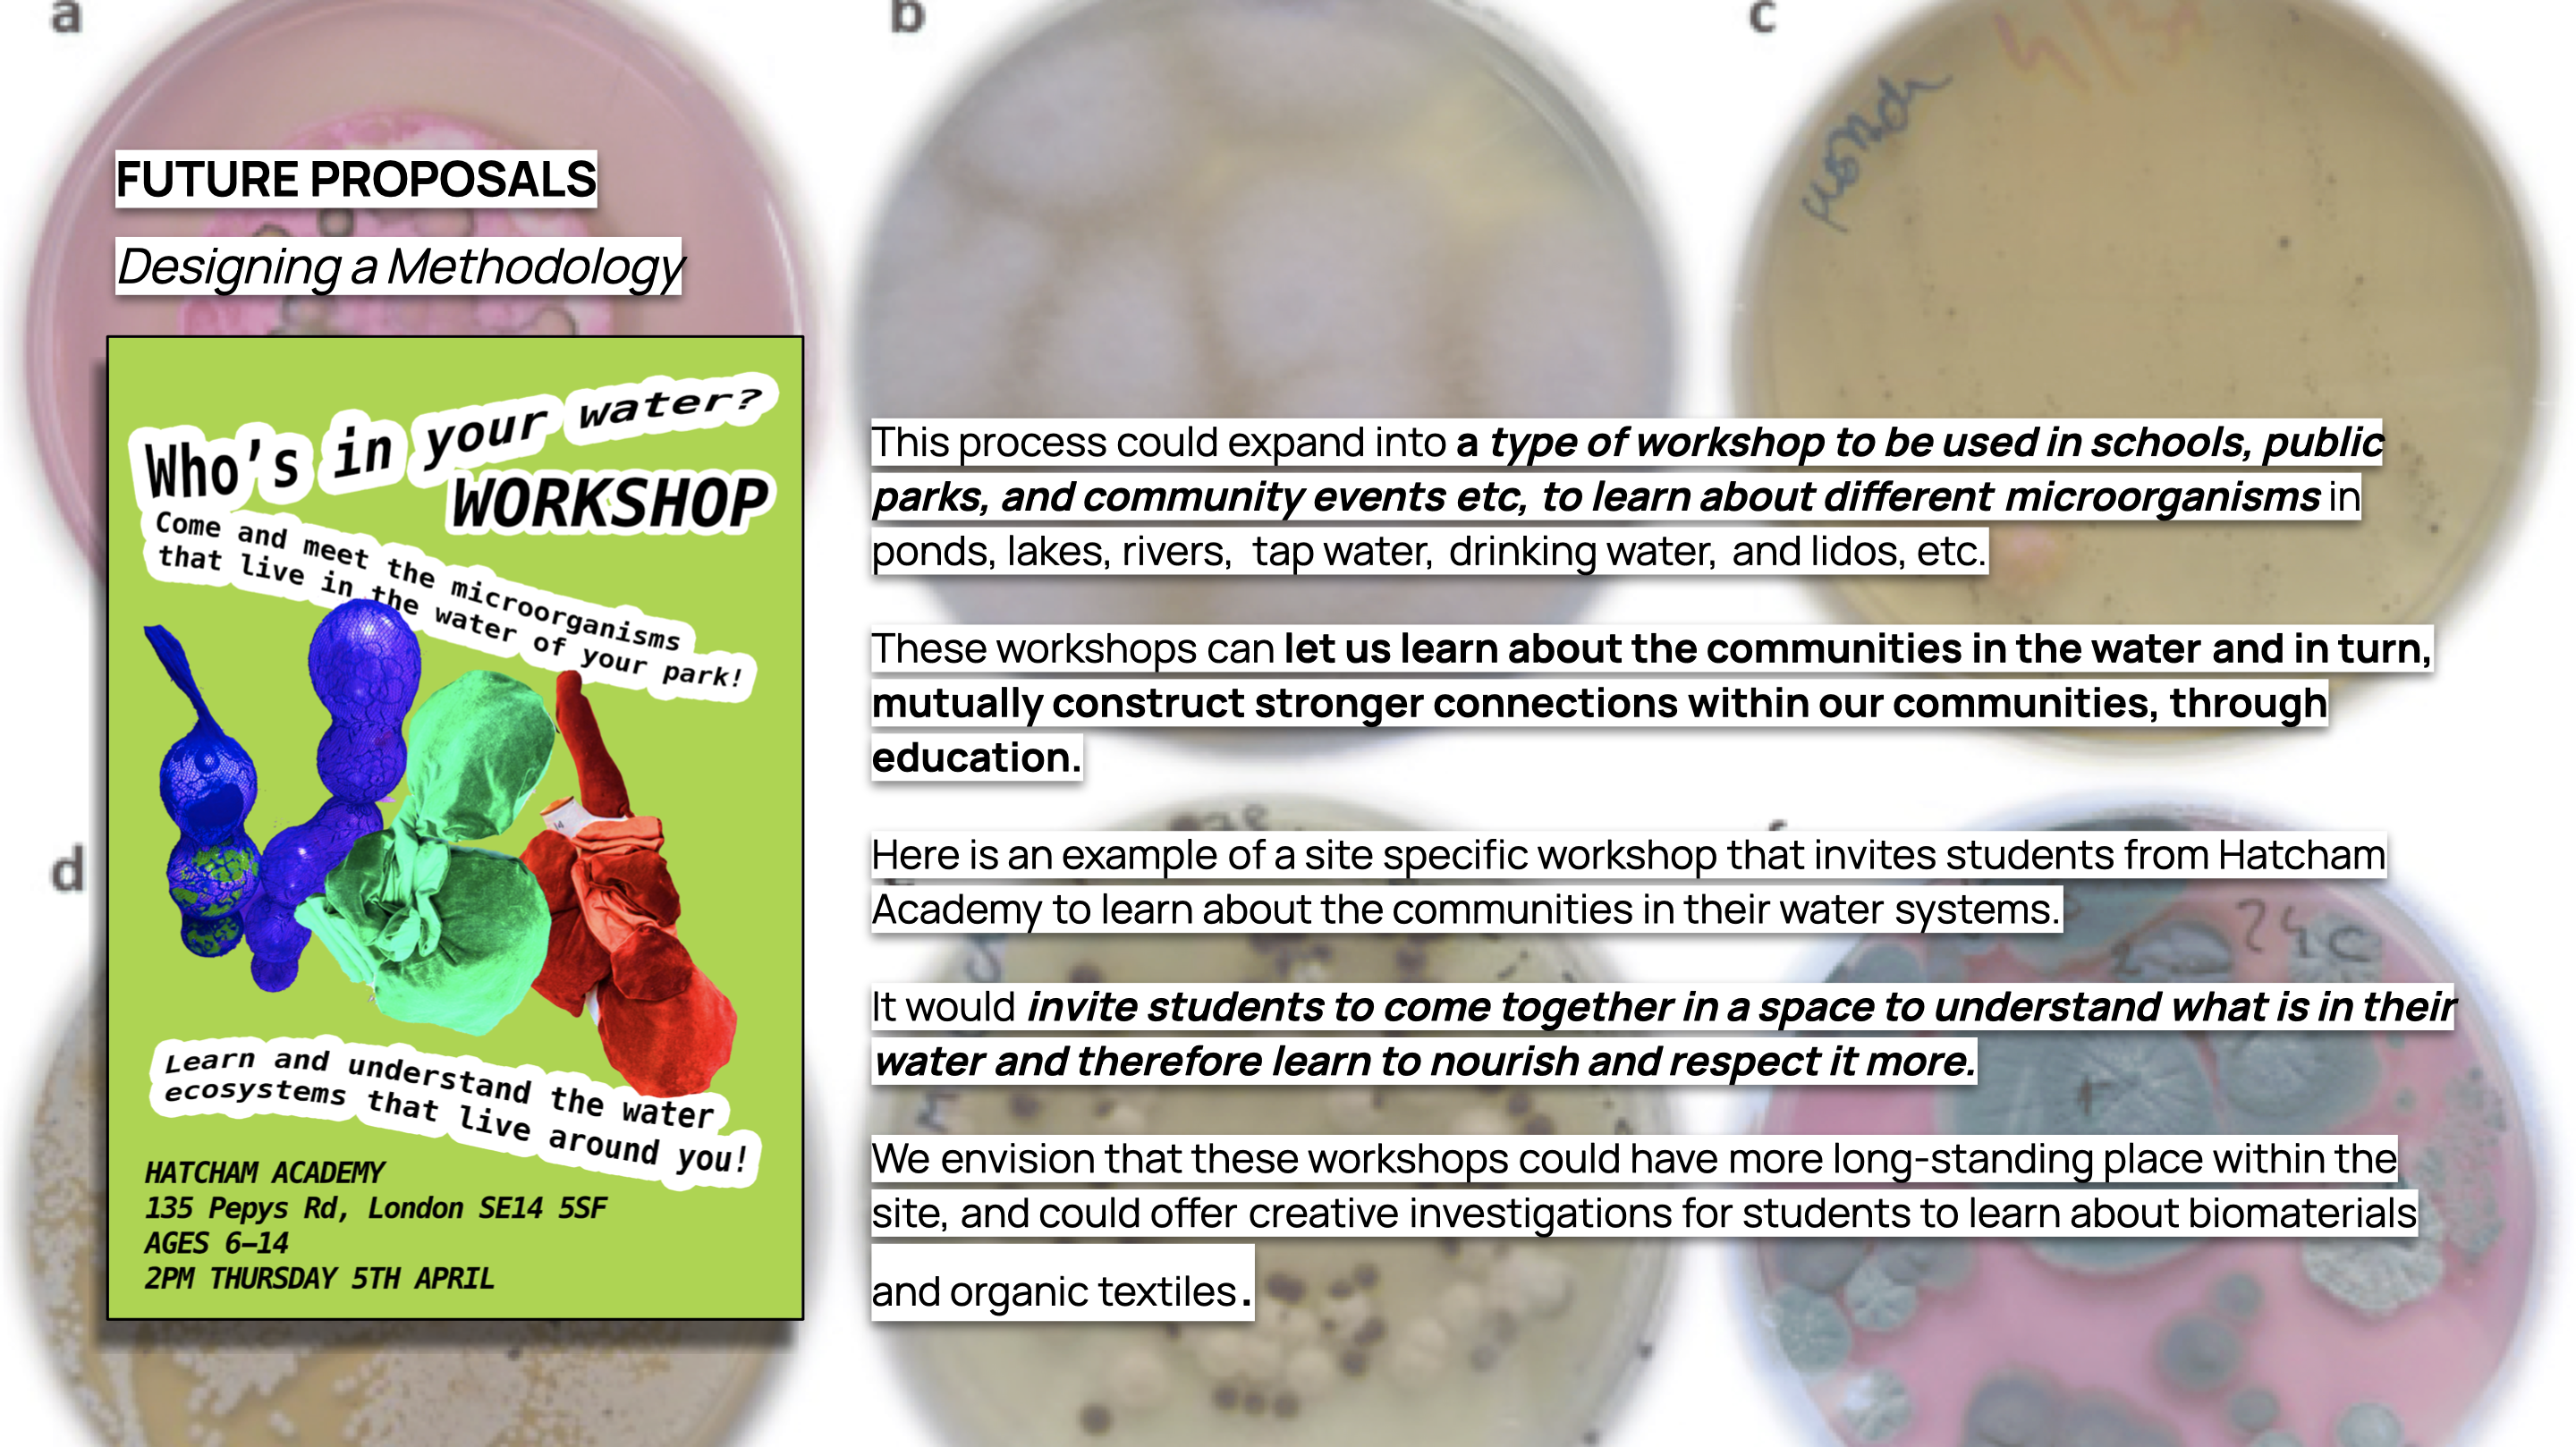

A R U P - LIVE
Goldsmiths, 2023
Throughout this project we explored past and present communities around Peckham Rye Lido and used our proposal to look at what it means to create community around and inside the water ecosystem.
Thinking about how we mutually interact with water, specifically within the River Peck, we want to advocate for water to be treated as more than a resource from our taps and a growing, living thing.
Our proposal gives an opportunity for people to pause, learn, and educate themselves about the importance of water and the communities that are in it.
Community: Locals of Peckham Rye
Site: Peckham Rye x The River Peck
Goal: Educate Peckham’s local communities about the importance of what’s in their water in the area and in their own wet spaces

What does a current day water space look like for today’s communities in Peckham Rye ?
MAPPING




Film: Discovering and Uncovering Peckham RyeMAPPING WATER ECOSYSTEMS


Film: A Microscopic Investigation
Our proposal is to create an immersive experience of microorganisms that activates people’s perceptions of water as a and living through educating in a fun and engaging way.
We created a series of wearable costumes based around the different microorganisms that visualise the ecosystem of the River Peck.
The costumes and interactions personify the microorganisms and introduce the public to this water community.


DESIGNING OUR INTERVNETION
LIFE WITHIN WATER
Why we chose them and what we need to know:Today we see water as a resource that is utilized and manipulated in our everyday lives for our own gain.
It is important to understand that water is living and has its own ecosystems within it that are not visible to the human eye.
There are microscopic living organisms in water, and we must understand that the things we can’t see, we value less.
Our perception of ‘good water’ derives from the health of consuming it into a human body, and identifying bacteria that is ‘unhealthy’ for humans to consume. But water that is ‘not good’ for humans to consume, is water that can construct a healthy living moving ecosystem, that provides life in different ways to drinking out of our taps. We want to personify the water and the microorganisms in it, to reach a new understanding of what ‘good water’ is.






ON SITE:




Film: A MicroOrganism Interaction